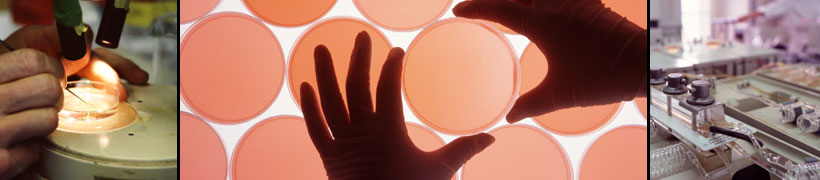

The Emerging Industries Practice – Retaining Top Talent through the Cycles of Business Growth
MKA understands industries that may redefine our future are filled with challenges that often depend on talented scientists, professionals and executives. These dedicated contributors are pivotal players in break-through discoveries that often catapult businesses to new levels overnight. Our professional business transition team specializes in financial strategies designed to reinforce retention of key employees, along with the protection of investors against loss of key persons due to death or disability. We help keep your key players focused on pioneering change while designing customized plans to help them share in success. Through developing programs that help employee retention and insure against loss due to death or disability, MKA assists in reinforcing the investment made in businesses that shape the future. We specialize in key employee retention plans, business continuation planning and business evolution planning.
The Importance of Board & Community Relationships
As experienced senior executives who have successfully presented to hundreds of Boards, we understand your fiduciary responsibility. Our recommendations for top management benefits are consistent with your governing body’s legal, ethical and business expectations. Relationships with the Board as well as the surrounding community are uppermost in all our considerations.
What You Can Expect from MKA as Your Strategic Advisor
Our approach is simple: gain a comprehensive understanding of your needs and then collaborate on a strategic plan to help achieve your objectives. We are not transaction focused. MKA’s team of transition strategy professionals combine their 150 years of experience, expertise and talents to design and implement a program for your approval. MKA's Emerging Industries practice is managed by senior experienced professionals who know the industry. We promise and deliver substance not pretense.